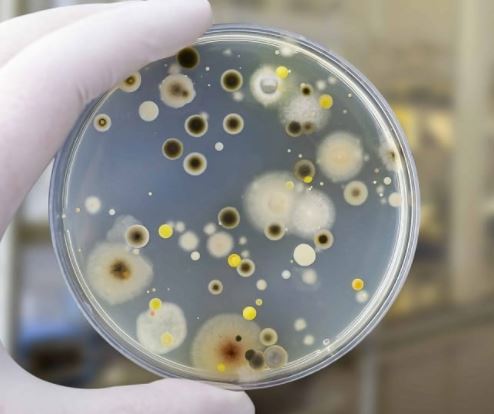

Skimmelsvamp bekæmpelse: Fra hjemmeremedier til professionel hjælp
Når skimmelsvamp gør sit indtog i vores hjem, er det afgørende at handle hurtigt. Heldigvis findes der en række effektive DIY-metoder, naturlige løsninger og professionelle tilgange, som du kan tage i brug. I dette afsnit dykker vi ned i, hvordan du kan bekæmpe skimmelsvamp selv, og hvornår det er tid til at ringe efter de professionelle.
Hvis du mistænker skimmelsvamp i dit hjem, kan du finde Danmarks billigste skimmelsvamptester her.
DIY-løsninger til små områder af skimmelsvamp
Er du stødt på et mindre angreb af skimmelsvamp, kan du ofte selv tage kampen op. Forudsat at området er mindre end ca. en halv kvadratmeter, og du ikke lider af astma eller allergi, kan følgende metoder være effektive:
Rengøring med sæbevand: En simpel blanding af opvaskemiddel og vand kan bruges til at skrubbe skimmelsvamp væk fra ikke-porøse overflader. Husk at bruge handsker og maske for at beskytte dig selv.
Brug af skimmelsvampespray: Disse findes i de fleste byggemarkeder og kan være en nem løsning til små områder.
Hvid eddike: Sprøjt ufortyndet hvid eddike på det ramte område, lad det sidde i en time, og tør efter med vand. Eddike dræber op til 82% af skimmelsvamparter.
Bagepulver og vand: En tyk pasta af bagepulver og vand kan anvendes på området, lad det tørre, og skrub så området rent.
Hydrogenperoxid: En 3% opløsning af hydrogenperoxid kan sprøjtes på skimmelsvamp, lad det virke i 10 minutter, og tør efter med en klud.
Naturlige midler mod skimmelsvamp
For dem, der foretrækker at undgå kemikalier, er her nogle naturlige alternativer:
Eddike: Som nævnt ovenfor er eddike et kraftfuldt naturligt desinfektionsmiddel.
Tea tree olie: Bland en teskefuld tea tree olie med en kop vand og sprøjt direkte på skimmelsvampen. Du skal ikke skylle efter, da olieresterne vil fortsætte med at bekæmpe skimmelsvamp.
Grapefrugtkerneekstrakt: Ligesom tea tree olie, blandes grapefrugtkerneekstrakt med vand og påføres området uden efterfølgende skylning.
Rengøringsalkohol: Sprøjt rengøringsalkohol på det inficerede område, lad det sidde, og tør derefter af.
Hvornår og hvordan man skal hyre en professionel til skimmelsvampsanering
Der er situationer, hvor det er bedst at lade de professionelle tage over for din skimmelsvamp bekæmpelse:
Størrelsen på angrebet: Hvis skimmelsvampen dækker et større område end en halv kvadratmeter, bør du overveje professionel hjælp.
Hvis skimmelsvampen vender tilbage: Dette kan tyde på et dybere problem, som muligvis involverer din boligs struktur.
Sundhedsrisici: Har du eller din familie helbredsproblemer, som kunne forværres af skimmelsvamp, er professionel sanering nødvendig.
Hvis skimmelsvampen er i ventilationssystemet: Dette kræver særlige værktøjer og metoder, som de fleste husejere ikke har til rådighed.
At finde det rette firma til din skimmelsvamp bekæmpelse, kræver lidt forskning. Sørg for at vælge nogen med god erfaring og de nødvendige certificeringer. Få gerne flere tilbud og spørg ind til deres processer og de midler, de bruger. Det er også en god idé at tjekke anmeldelser og referencer fra tidligere kunder.
Står du og mangler et middel mod skimmelsvamp? Læs mere om fjernelse af skimmelsvamp her.
Skimmelsvamp kan være en udfordring, men med de rette værktøjer og viden kan du sikre dig og din familie et sundere indeklima. Og husk, at nogle gange er den bedste løsning at lade de erfarne professionelle tage over.